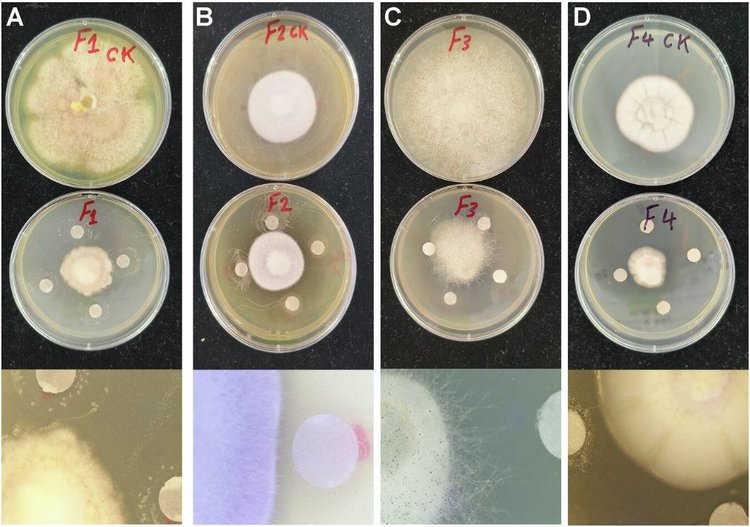
Одна пустынная эндофитная бактерия может привести к новым средствам защиты растений

Удобрения дорожают: фермеры все чаще смотрят на водорослевые биостимуляторы для культур
Исследователи из Института Джеймса Хаттона, работающие над совместным проектом по изучению того, как экстракты ламинарии сахаристой, прежнее название бурой водоросли сахарина большая, могут улучшить управление питательными веществами в сельском хозяйстве, сообщили о многообещающих результатах контролируемого эксперимента в теплице. Целью эксперимента было определить, могут ли такие экстракты улучшить усвоение питательных веществ в условиях ограниченного количества удобрений. Испытание было сосредоточено на смягчении последствий недостатка азота в ячмене и недостатка фосфора в фасоли.